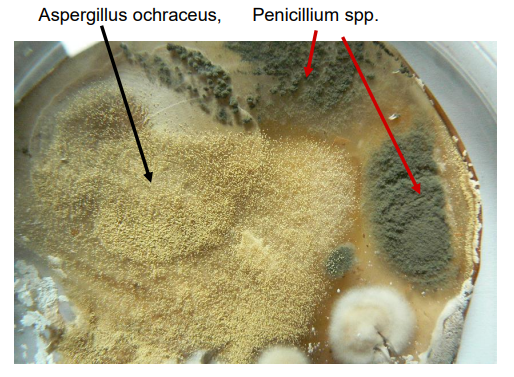
<p>rząd: Eurotiales</p>

1/63
Looks like no tags are added yet.
Name | Mastery | Learn | Test | Matching | Spaced | Call with Kai |
|---|
No analytics yet
Send a link to your students to track their progress
Myxomycetes - śluzowce właściwe
-organizmy grzybopodobne (Amoebozoa)
-ściana kom: galaktozoamina (obecna tylko przed wytwarzaniem zarodników)
-mat. zap: glikogen i tłuszcze
-stadium wegetatywne: śluźnia (plasmodium), faza dominująca 2n
-odżywianie: fagocytoza

cykl życiowy śluzowców
-2 typy spor (1n):
—komórka ameboidalna (środowisko lądowe)
—komórka uwiciona (środowisko wodne) ma 2 wici oraz nibynóżki [zoospora]
-w sytuacji stresu/niekorzystnych warunków:
—hamowanie wzrostu
—jądra kom migrują tworząc sporangia (zarodnie)
—cała cytoplazma migruje do zarodników, jej resztka tworzy sporangium (oraz trzonek i leżnie) [te struktury mają ścianę komórkową]
—zachodzi synchroniczna mejoza - powstają spory
![<p>-2 typy spor (1n): <br>—komórka ameboidalna (środowisko lądowe)<br>—komórka uwiciona (środowisko wodne) ma 2 wici oraz nibynóżki [zoospora]</p><p>-w sytuacji stresu/niekorzystnych warunków:<br>—hamowanie wzrostu<br>—jądra kom migrują tworząc sporangia (zarodnie)<br>—cała cytoplazma migruje do zarodników, jej resztka tworzy sporangium (oraz trzonek i leżnie) [te struktury mają ścianę komórkową]<br>—zachodzi synchroniczna mejoza - powstają spory</p>](https://knowt-user-attachments.s3.amazonaws.com/af8e99f5-4ecf-4b9a-813c-1d8b4d94043e.png)
typy owocowań śluzowców
-plasmodiocarp
-aetalium
-pseudoaetalium
-sporangium (zarodnia właściwa)

Sporangium (zarodnia właściwa) śluzowców
-zarodnia siedząca lub na trzonku
-zaopatrzona we włośnię (na której osadzone są zarodniki)
-zwykle tworzona w grupach na jednej leżni
-włośnia typu capillitium
-np. Physarum album

plasmodiocarp śluzowców
-nieregularna sieć śluźni z wykształconą ścianą
-zarodniki znajdują się w środku
-np. Hemitrichia serpula

Aetalium śluzowców
-siedzące, workowate owocowania
-stosunkowo duże
-otoczone wspólną ścianą komórkową
-zarodnie są jedną wspólną strukturą
-np. Lycogala epidendrum

pseudoaetalium śluzowców
-małe, siedzące zarodnie
-tworzą zwartą strukturę
-nie posiadają wspólnej ściany komórkowej

włośnia śluzowców
-struktura ułatwiająca rozsiewanie się zarodników
—budując wyniesione rusztowanie (capillitium) - Stemontis sp.
—aktywnie wyrzucając zarodniki - elatery (reagują na wilgoć, ścianki spiralnie zgrubiałe) - Trichia sp.
-tworzona na skutek odkładania minerałów w wakuolach

Oomycetes - lęgniowce
-organizmy grzybopodobne (Stramenopila, Heterokonta)
-ściana kom: celuloza i betaglukan
-mat. zap: mykolaminaryna
-”pseudo” strzępki syfonalne, faza dominująca 2n
-odzywianie: osmotrofia (saprotrofy i pasożyty wodne)
-na zdj. Saprolegnia sp.

lęgniowce cykl życiowy
-na końcach pseudostrzępki poprzez odcięcie ścianą komórkową powstają lęgnie i plemnie
-plemnie przyklejają się do lęgni, wytwarzają filamenty dochodzące do kom. jajowych (oogamia)
-oospora ma grubą ścianę komórkową (jest to pseudogrzybnia)

zoospory lęgniowców
-diplanetyzm - występowanie 2 typów zoospor
-zoospory 2-wiciowe
-zoospora I rzędu - pływka ucieczkowa (2n)
—ucieka od materiału macierzystego substratu
—traci wić
—zamienia się w cystę
-zoospora II rzędu - pływka poszukująca (2n)
—płynie w stronę większego stężenia aminokwasów/azotu/węgla
—może zmienić się w cystę lub kiełkować w wybranym miejscu

znaczenie lęgniowców
-duże znaczenie ekonomiczne
-kształtowały cywilizację
-zaraza ziemniaczana (Phytophthora infestans)

Fungi - grzyby
-należą do opisthokonta
-ściana kom: chityna
-mat. zap: glikogen i tłuszcze
-organizmy heterotroficzne - osmotrofia (trawienie zewnętrzne)
Chytridiomycota - skoczaki
-wodne, biofilm w glebie
-słabo rozwinięte morfologicznie
-plechy jednokomórkowe (monocentryczne)
-pasożyty lub saprotrofy (osmotrofia)
-dominująca faza w cyklu życiowym - 1n
-na zdj. Rhizophydium pollinis-pini

cykl życiowy skoczaków
-różne cykle życiowe
-tylko zarodnie przetrwalne są 2n

Mucoromycota - pleśniaki
-grzyby lądowe
-strzępki bez przegród (plecha syfonalna lub syfonokladialna)
-faza dominująca - haplofaza (1n)
-saprotrofy glebowe związane z substratami roślinnymi (osmotrofia)

cykl życiowy pleśniaków
-brak zoospor, występują aplanospory
-występują różne typy płciowe ±


plasmogamia pleśniaków

Mucor sp. (pleśniak)

Pilobolus sp. - pleśniak
-pospolity grzyb koprofilny (kupy roślinożerców)
-zarodnie trwałe, grubościenne (odrzucane aktywnie - ciśnienie hydrostatyczne spowodowane ogrzaniem kupy)
-sporangiofory fototroficzne

Zoopagomycota - zwierzomorkowe (rząd Entomophthorales)
-bardzo pospolite
-pasożyty owadów (ale też np. żab)
-aktywnie wystrzeliwują zarodniki/sporangia
-brak zoospor
-osmotrofy związane z substratami zwierzęcymi
-cykl:
—zarodnik spada na muchę
—rozpuszcza chitynę
—tworzy galaretowate kłębuszki z grzybni (podróżują one hemolimfą)
—trawi muchę od środka (pozostawia tylko mięśnie skrzydeł)
—mucha szuka eksponowanych miejsc
—grzyb zabija owada
—owad eksponuje odwłok, co zachęca samca do przylecenia i zakażenia się
-na zdj. Entomophthora muscae

Cechy wspólne Ascomycota (workowce) i Basidiomycota (podstawczaki)
-wspólny przodek
-brak stadiów uwicionych (zarodniki bez przydatków)
-dikariofaza (n+n) obecna - tylko tutaj (królestwo Dikaria)
-obecne strzępki z przegrodami
-formowanie zarodników w owocnikach po procesie płciowym
-mejoza prawie natychmiast po kariogamii (powstanie zarodników)
Basidiomycota - podstawczaki
-obecna somatogamia (zlewanie się strzępek)
-obecne sprzążki- bypassy
-grzybnia i owocnik dikariotyczny
-zarodniki (po 4 najczęściej) znajdują się na podstawce

Basidiomycota - cykl rozwojowy
-basidiospory (zarodniki podstawkowe) kiełkują
-grzybnia haploidalna najczęściej obumiera jeśli nie dojdzie do somatogamii
-w owocniku obecny hymenofor (struktura wynosząca hymenium - tam znajdują się podstawki)

basidium (podstawka)
-na zdj. pieczarka dwuzarodnikowa (2 basidiospory zanikają)
-pomiędzy zarodnikiem a sterygium - kropla Bullera (miejsce przesączania się płynów z podstawki) - przeskakując na zarodnik wystrzeliwuje go
-na zdj. Agaricus bisporus

typy podstawek
-holobasidia (niepodzielne)
-fragmobasidia (podzielne, np. u rdzy)

owocnik angiokarpiczny
-zarodniki są zamknięte w środku (przez perydium)
-zarodniki osadzone są na włośni (grubościenne filamenty)
-na zdj. Lycoperdon sp.

owocnik hemiangiokarpiczny
-pierwsze stadium - czarcie jajo/prinordium
-osłona całkowita pęka w trakcie rozwoju owocnika, zostaje w postaci pochwy + skorupki na kapeluszu
-osłona częściowa - błonka chroniąca blaszki (zostaje czasem w postaci pierścienia)
-trama- wypełnienie części płonej

Amanita phalloides
-muchomor sromotnikowy
-hepatotoksyny (niebezpieczny też ze względu na fazę ukrycia)
wygląd:
-obecna pochwa i bulwa
-biały pierścień i blaszki
-łubiasty trzon z zygzakowatym wzorem
-żółtawo-zielonkawe zabarwienie
-słodkawy, nieprzyjemny zapach

owocnik gymnokarpiczny
-hymenium eksponowane przez całe życie owocnika
-hymenofor rurkowaty ustawiony otworami w dół


rząd: Agaricales - pieczarkowce
-należy do Basidiomycota


rząd: Polyporales - porzycowe (huby)
-należy do Basidiomycota
-np. Fomitopsis betulina, Fomes fomentarius, Daedalea quercina
rząd: Pucciniales - rdzowce
-należy do Basidiomycota
-wyłącznie pasożyty roślin (biotrofy obligatoryjne) (wiele ma więcej niż jednego żywiciela)
-mają podzielne podstawki (fragmobasidie)
-sprzążki nie występują

Pucciniales cykl rozwojowy
-rdza źdźbłowa Puccinia graminis
zarodniki:
wiosna
-basidiospory (1n) cel- infekcja berberysu (cienkościenne)
-pyknospory (1n) cel- dikariotyzm
-ecydiospory (1+1) cel- infekcja trawy (powstają w łańcuchach)
lato
-uredospory (1+1) cel- infekcja kolejnych traw (kolczaste)
zima
-teliospory (1+1) cel- przetrwanie zimy (grubościenne, silnie zmelanizowane)

Pucciniales cykl rozwojowy
we wiosne: góra liścia - pyknidium, spód - ecydium

Ascomycota - workowce
-strzępki wegetatywne z przegrodami (1n)
-strzępki workotwórcze (n+n - tylko te!)
-występuje gametangiogamia (połączenie plemni i lęgni)
-8 zarodników (aksospor) w worku

rząd: Saccharomycetales - drożdżakowce
-jednokomórkowe (1 lub 2n - brak dikariofazy)
-brak strzępek workotwórczych (czasem pseudo)
-worki prototunikowe (4 lub 8 zarodników)
Saccharomycetales - cykl życiowy
komórka pączkująca drożdży może być zarówno haplo jak i diploidalna
-na przykładzie: Saccharomyces cervisiae

“Porosty”
-forma życiowa grzybów (w większości należących do workowców - do rzędu Lecanoromycetes, nieliczne podstawczaki)
-składają się z mykobiontu (minimum 1 grzyb lichenizujący) i fotobiontu (glon - zielenica, sinica)
-mogą żyć w ekstremalnych środowiskach
typy plech porostów
homeomeryczna - bezładny rozrzut grzybni (która tworzy stelaż) i komórek glona
heteromeryczna - ułożona warstwami
-w. korowa górna (ściśle ułożona grzybnia)
-w. gonidialna (grzybnia luźniejsza, dużo komórek glona)
-w. rdzeniowa (luźno ułożona grzybnia - akumulacja wody)
-w. korowa dolna (często z chwytnikami)


rozmnażanie porostów
płciowe - owocnik miseczkowaty - wtedy rozmnaża się sam grzyb
wegetatywne - rozmnażają się i grzyby i porosty
-soredia (urwistki) - wyglądają jak małe kuleczki - Hypogymnia physodes
-izydia (wyrostki) - wyglądają jak najeżone igiełki - Pseudevernia furfuracea

rodzaje plech porostów

Xanthoria parietina

cykl życiowy workowców
-strzępki spotykają się
-zachodzi gametangiogamia - powstaje strzępka dikariotyczna
-na końcu strzępki do chodzi kariogamii
-mejoza + mitoza = 8 akrospor

budowa owocnika workowców
-zbudowany z worków ułożonych na hymenium
-różne typy strzępek:
—n+n
—2n tymczasowe, szybko zachodzi mejoza
—n akrospory
-struktury homologiczne do sprzężek - haczyki (tam migruje jedno jądro komórkowe, może zlać się ze strzępką aby uzyskać n+n i utworzyć nowy worek)

typy worków - protunikowe
-pojedyncza ściana która ulega lizie, zarodniki wypadają
-np. drożdze (Saccharomycetes cervisiae)

typy worków - unitunikowe
-jedna ściana, ale grubsza i posiadająca mechanizmy rozpraszania zarodników
—operculate (wieczkowe)
-wieczko usuwane w sposób “eksplozywny”
-widoczny pyłek/dym zarodników
—inoperculate (bezwieczkowe)
-widoczny pierścień u szczytu komórki
-wypycha zarodniki
-mazista kropla na szczycie worka

typy worków - dwuścienne
-zewnętrzna ściana jest sztywna i pęka pod wpływem turgoru
-wewnętrzna ściana jest elastyczna - “eksplozywnie” wypuszcza zarodniki przez otwór

typy owocników workowców - klejstotecjum
-”kuleczki”
-brak otworu
-trwałe perydium
-uwolnienie zarodników przez uszkodzenie owocnika
-brak hymenium, bezładny układ worków
-obecne przyczepki
-np. Ersiphe palczewskii

typy owocników workowców - perytecjum
-”buteleczki”
-otwór na szczycie (ostiola)
-jest hymenium i na nim osadzone worki
-mogą być w pełni na powierzchni lub schowane
-mogą znajdować się na podkładce (struktura “udająca” owocnik) - Claviceps purpurea
-np. Sordaria sp. Podospora sp., Nectria sp., Chaetomium sp.

typy owocników workowców - apotecjum
-”miseczka”
-hymenium po wewnętrznej stronie “miski”
-może być zmodyfikowana (z trzonem i “pogiętą” miseczką - zwiększenie powierchni)
-np. Helvella crispa, Morchella sp., Peziza sp., Rhizina undulata, Aleuria sp., Mollusia sp., Hymenoscyphus sp.


rząd: Erysiphales - mączniaki prawdziwe
-należy do Ascomycota
-obligatoryjne biotrofy - pasożyty roślinne
-”mąka” na powierzchni liścia/łodygi
-tworzy haustoria (ssawki) - nie przebija błony komórkowej rośliny
-owocnik typu klejstotecjum
-np. Erysiphe palczewskii

rząd: Sordariales
-żyją na drewnie/silnie rozłożonych materiałach roślinnych (też kupy roślinożerców)
-najczęściej owocnik typu perytecjum
Xylaria polymorpha
-rząd Sordariales (Ascomycota)
-tzw. “palce umarlaka”
-podkładka - tkanka w której znajdują się perytecja, na zewnątrz wystają tylko ostiole

Chaetomium sp.
-rząd Sordariales (Ascomycota)
-perytecjum
-”fryzury” specyficzne dla gatunków

Claviceps purpurea
-rząd Hypocreales (Ascomycota)
-tworzy tzw. sporysze - przetrwalniki - na nim wyrastają podkładki z perytecjami
-pasożyt traw (w tym zbóż)
-sporysz jest fabryką metabolitów wtórnych
-choroba ergotyzmu “spalał stopy grzeszników”
-ergotyzm: gangrenowy lub konwulsyjny

rząd: Pezizales - kustrzebkowce
-należy do Ascomycota
-owocniki typu apotecjum

Aleuria aurantia
-rząd: Pezizales - kustrzebkowce (Ascomycota)
-typowy apotecjum

Ascomycota - anamorfy
-synonimy: grzyby anamorficzne, grzyby konidialne, grzyby mitosporowe, pleśnie, strzępczaki
-rozmnażanie bezpłciowe (strzępki haploidalne, zarodniki powstają na drodze mitozy)
-forma grzybów (jedna forma telomorficzna, może być wiele form anamorficznych)
typy konidiów - workowce anamorfy
Konidia = zarodniki mitotyczne/wegetatywne
Tallokonidia
-rozpad strzępki wzdłuż ścian poprzecznych na tallokonidia
Blastokonidia holoblastyczne
-komórka wypączkowuje komórkę potomną - obie części ściany biorą udział
Blastokonidia enteroblastyczne
-komórka wypączkowuje komórkę potomną - komórka tworzy się tylko z wewnętrznej części ściany

Łańcuchy konidiów - workowce anomorfy
Basipetalne
-komórka konidiotwórcza jest zawsze aktywna, tworzy konidia
-najmłodsze konidia znajdują się przy komórce konidiotwórczej (tu Fialidy)
-łańcuchy mogą być długie, ale łamią się z rozrostem
-np. Penicillium sp., Aspergillus sp.
Akropetalne
-komórka konidiotwórcza tworzy pierwsze konidium, kolejne są tworzone przez poprzednie konidia
-najmłodsze konidium znajduje się na szczycie
-łańcuchy raczej krótkie (z podziałami coraz mniej materiału)
-np. Alternaria sp., Cladosporium sp.

rząd: Eurotiales
-należy do Ascomycota (anamorficznych)
-fialidy - komórki konidiotwórcze (znajdują się na metulach)
-np. Penicillium sp., Aspergillus sp.


rząd: Pleosporales
-należy do Ascomycota (anamorficznych)
Alternaria sp.
-rozkłada szczątki roślinne
-porokonidium specyficzne dla tego gatunku!

rząd: Capnodiales
-należy do Ascomycota (anamorficznych)
Cladosporium sp.
-występują blastokonidia holoblastyczne i talokonidia (konidiofory chętnie się łamią)
